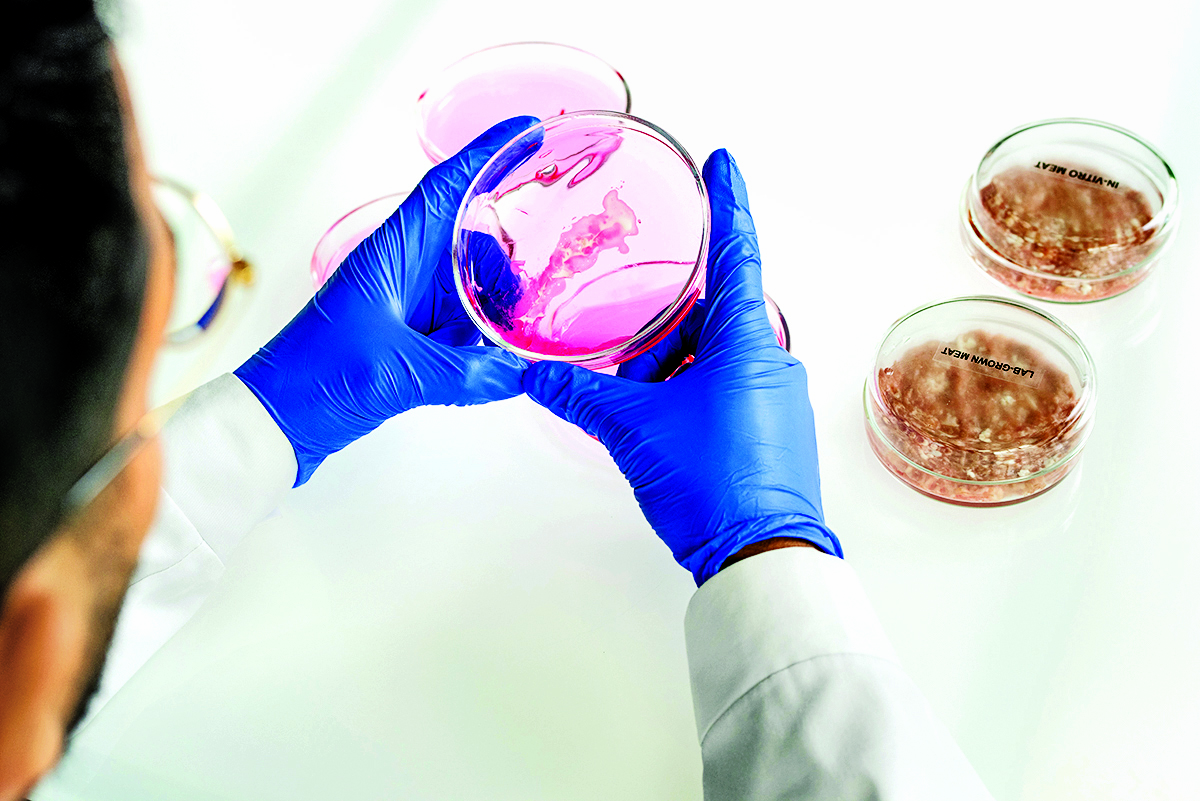

كشف المجلس الوطني للتخطيط أن عدد السكان داخل دولة قطر بلغ في نهاية شهر نوفمبر (3,340,858) نسمة. وبذلك يرتفع عدد سكان دولة قطر...
رئيس مجلس الإدارة : د. خالد بن ثاني آل ثاني

رئيس التحرير: جابر سالم الحرمي

مساحة إعلانية
مساحة إعلانية
أكّد الدكتور محمد أسامة الحمصي- استشاري أول علاج الأورام ونائب المدير الطبي للجودة والبحث والتعليم الطبي بالمركز الوطني لعلاج وأبحاث السرطان بمؤسسة حمد الطبية-، التطور الذي شهده المركز الوطني لعلاج وأبحاث السرطان بصورة خاصة ومؤسسة حمد الطبية بصورة عامة زاد ثقة المرضى، وأسهم في خفض نسب المرضى من المواطنين الذين يتوجهون للعلاج في الخارج.
وحذر د. الحمصي في حوار مع "الشرق" من الانسياق وراء العلاجات الشعبية والخلطات العُشبية التي تُسوق عبر وسائل التواصل الاجتماعي على أنها علاجات مضمونة لمرض السرطان، فما قد تخلفه من أضرار يتجاوز المنافع بمراحل.
وأعلن توسيع منطقة الرعاية اليومية للمرضى في مركز علاج وأبحاث السرطان مع زيادة في عدد أسِّرة المرضى، فيما تمت الاستفادة من مرافق مركز الرعاية الطبية والبحوث الجديدة، كما أدخل الذكاء الاصطناعي في العلاج الإشعاعي، فبالاستناد إلى تقنية الذكاء الاصطناعي يتم تحديد موقع الورم السرطاني بدقة وهذا يؤدي لتقليل مخاطر التعرض للعلاج الإشعاعي للأنسجة والأعضاء المجاورة. وكشف د. الحمصي النقاب عن أنَّ آخر إحصائية صادرة عن سجل قطر الوطني للسرطان في عام 2020 سجلت 2042 حالة جديدة بين المواطنين والمقيمين من كلا الجنسين، وقد تصدر سرطان الثدي في القائمة بنسبة 16 %، يليه سرطان القولون بنسبة 9 %، ومن ثم سرطان الغدة الدرقية بنسبة 8 %.

- خدمات المركز الوطني
كيف نعرِّف السرطان؟
السرطان هو نمو غير طبيعي للخلايا التي يمكن أن تبدأ في أي مكان في الجسم وتدريجيا ممكن أن تؤدي إلى تكاثرها وتجمعها لتشكل كتلة ورمية يزداد حجمها مع الوقت. واذا لم تكتشف في وقت مبكر. فمن الممكن أن تنتقل الى أي جزء من الجسم مثل العظام أوالأعضاء الداخلية والدماغ، وحتى الآن لا توجد دراسة مؤكدة تشير بإصبع الاتهام إلى سبب بعينه لتحمله مسؤولية انتاج هذه الخلايا السرطانية، وإنما هناك عدة عوامل ممكن أن تسهم في إنتاج هذه الخلايا غير الطبيعية وبالتالي إصابة الشخص بالسرطان.
ما هي الخدمات التي يقدمها المركز الوطني لعلاج وأبحاث السرطان للمرضى؟
يقوم المركز الوطني لعلاج وأبحاث السرطان بتقديم الرعاية الشاملة والمتكاملة لمرضى السرطان ممن هم بحاجة إلى الخدمات العلاجية الدوائية كالعلاج الهرموني والعلاج الكيميائي والعلاج المناعي والعلاج الموجه، وكذلك العلاج الإشعاعي، كما يقدم المركز الوطني لعلاج وأبحاث السرطان خدماته في علاج اضطرابات الدم الحميدة والخبيثة، وكذلك عمليات زرع النخاع العظمي، هذا بالإضافة إلى توفير الرعاية التلطيفية، وعيادة معالجة الألم، ومن المهم الإشارة إلى أنَّ المركز يوفر بيئة تساعد على التعافي، حيث إنها تركز على تقديم رعاية عالية الجودة للمرضى مع اعتماد أحدث التقنيات والمنهجيات المُتبعة لتقديم علاجات السرطان ذات المستوى العالمي بشكل يتسق وخطة قطر للسرطان، ويشمل قسم استقبال المرضى الداخليين، والعيادات الخارجية، والعلاج الدوائي الوريدي في وحدة الاقامة اليومية، وقسم المرضى الداخليين لفترات قصيرة، إضافة لقسم الرعاية العاجلة للحالات الطارئة والخدمات الاستشارية الوراثية.
- إحصائية السرطان
ما هي السرطانات الأكثر شيوعا في دولة قطر ؟
قبل الحديث عن أكثر السرطانات شيوعا في دولة قطر، من المهم التوضيح أنَّ الإحصائيات المعلنة هي إحصائيات صادرة عن سجل قطر الوطني للسرطان وهي جهة تتبع وزارة الصحة العامة، حيث انَّ آخر إحصائية صادرة عن السجل كانت حتى عام 2020 فكانت عدد الحالات بناء على الإحصائيات 2042 حالة بين المواطنين والمقيمين من كلا الجنسين، وقد تصدر سرطان الثدي في القائمة بنسبة 16%، يليه سرطان القولون بنسبة 9%، ومن ثم سرطان الغدة الدرقية بنسبة 8%، وسرطان الدم بنسبة 7%، وسرطان الدماغ والجهاز العصبي 4.8%، أما سرطان البروستاتا والرئة والقصبة الهوائية بنسبة 4%، وسرطان العقد اللمفاوية فكانت النسبة 3.8%، سرطان الجلد بنسبة 3.5% وسرطان الكبد بنسبة 3.4%.
لماذا يتصدر سرطان الثدي قائمة السرطانات الأوسع انتشاراً في المجتمع القطري؟
في حقيقة الأمر أنَّ سرطان الثدي لا يعد الأوسع انتشاراً في المجتمع القطري فحسب، بل يعد الأوسع انتشاراً على مستوى العالم، لذا يعد البرنامج الوطني للكشف المبكر عن سرطان الثدي من أهم البرامج على مستوى المنطقة في الكشف المبكر عن حالات الإصابة في وقت مبكر لتحقيق نسب شفاء قد تصل الى 95%، لذا على النساء اللاتي تنطبق عليهن شروط الفحص المبكر عدم إغفال الفحص المبكر عن سرطان الثدي وعنق الرحم لدوره في تحقيق نسب نجاح ستجعل السيدة تحيا حياة طبيعية.
- العلاج في المنزل
ماهي العوامل التي تسهم في الإصابة بالسرطان؟
في حقيقة الأمر هناك أسباب عدة تقف وراء الاصابة بمرض السرطان، منها نمط الحياة غير الصحي الذي يعتمد على قلة النشاط وعدم ممارسة أي نوع من أنواع الرياضة، إلى جانب استهلاك الأطعمة المصنعة والوجبات السريعة الخالية من أي فوائد والغنية بالدهون الضارة والسعرات الحرارية والكربوهيدرات التي تتحول إلى سكريات وتؤدي مجتمعة إلى السمنة وزيادة الوزن والتي أثبتت الدراسات أنَّ لها علاقة وثيقة في زيادة فرص الإصابة بالسرطان، كما أنَّ تدخين أنواع التبغ المختلفة أسهم في زيادة الإصابات، وبات الكثير من الشباب يلجأ إلى التدخين الإلكتروني كنوع من الوجاهة وظنا منهم بإنه أقل ضررا في حين أن هذه مقولة خاطئة فالتدخين الإلكتروني لا يقل ضررا عن التدخين المعتاد بل أضراره قد تتضاعف بسبب المنكهات المستخدمة، كما أن التوتر والقلق يضاعفان فرص الإصابة بالسرطان، إلى جانب أن الأشخاص المصابين بأمراض فيروسية كسرطان الكبد والذي ينتج عن التهاب مزمن بسبب فيروس الكبد الوبائي بنوعيه الـ(C- B)، وأيضا سرطان بسبب فيروس الورم الحُليمي البشري الذي قد يصيب عنق الرحم وأيضا قد يسبب سرطان البلعوم الأنفي وأحيانا قد يكون له علاقة بسرطان الثدي، إلى جانب الوراثة التي لها دور واضح في بعض أنواع السرطانات، لذا بدأنا بتقديم خدمة الاستشارة والفحص الجيني منذ عام 2013 والتي تعد جزءاً من عيادة الاستشارة الوراثية في المركز، حيث إنها توفر تقييماً شاملاً للمخاطر الجينية للمرضى الذين لديهم مخاطر الإصابة بالسرطان الوراثي أو وجود تاريخ عائلي للإصابة.
وأدعو في هذا السياق أولياء الأمور لمراقبة نوعية الأطعمة التي يقدمونها لأبنائهم، مع ضرورة تجنيبهم قدر المستطاع تناول الحلويات والسكريات وخاصة المصنعة والمليئة بالألوان والمنكهات الاصطناعية، أو الوجبات السريعة التي تسهم في السمنة لديهم وتزيد من فرص إصابتهم بالسرطان، وتعد اللوكيميا من أكثر السرطانات انتشارا بين الأطفال وسرطانات العظام وسرطانات الغدد اللمفاوية.
هل لكم أن تطلعونا إذا كانت هناك خدمات العلاج المنزلي قد تضاعفت؟، وما مدى جدواها من وجهة نظركم؟
إنَّ عدد المرضى المستفيدين من هذه الخدمة يشهد تزايدا مستمراً، حيث تتم متابعتهم من خلال الزيارات المنزلية المنتظمة من قبل فريق العناية التلطيفية من أطباء وممرضين، حيث تتم متابعة الحالات سريريا ونفسيا، وكذلك معالجة الالام وتخفيفها والمرضى متواجدون بالمنزل دون الحاجة للقدوم للمستشفى، وقد تم التأكد من نجاح هذه الخدمة بحيث يكون الأهل جزءا أساسيا من العملية والخطة العلاجية، وتدريجيا سيكون هناك زيادة في أعداد المرضى المستفيدين من هذه الخدمة، وهذا بالطبع سيتطلب زيادة في أنواع الأدوية المدرجة ضمن العلاج في المنزل، وأشير هنا إلى أنَّ الخدمة قد نالت رضا المرضى وذويهم، كما أصبح لدينا متسع لاستقبال أعداد أكبر من المرضى، لا سيما أنَّ علاج هؤلاء المرضى في المنزل يوفر راحتهم، مع زيادة الفرصة لاستقبال أعداد اكبر من المرضى المعالجين داخل المستشفى.
- خطة قطر للسرطان
خطة قطر للسرطان تهدف إلى تحسين الرعاية للمرضى، ما مدى تناغم هذا الهدف مع جهودكم المبذولة؟
إنَّ من أهم الأهداف هو أنَّ توفير كافة احتياجات المريض المصاب بالسرطان وتحسين جودة حياته، لذا خلال السنوات القليلة الماضية جرى توسيع الخدمات في الكثير من أقسام المستشفى مثل وحدة الحالات الطارئة، كما تم توسيع منطقة الرعاية اليومية للمرضى سواء الذين يتلقون علاجا كيميائيا أو مناعيا، كما تمت زيادة عدد الأسِّرة للمرضى داخل المستشفى، وتم كذلك الاستفادة من مرافق مركز الرعاية الطبية والبحوث الجديد، كما أن توفير الرعاية الصحية في المنازل تضاف إلى جهودنا المتناغمة مع خطة قطر للسرطان وهناك فريق متخصص لتقديم الرعاية التلطيفية ويقوم الفريق الطبي بزيارتهم في المنازل مرتين بالأسبوع لتأمين الرعاية اللازمة لهم.
إضافة لذلك توفير الرعاية النفسية للمرضى، فهناك أطباء متخصصون في الطب النفسي يقدمون الرعاية والدعم النفسيين التي يحتاجها مرضى السرطان وخاصة عند تشخيص المرض فيتم مساعدتهم لفهم طبيعة المرض ومراحل العلاج، وتبديد المخاوف التي تشاع عن هذا المرض.
ومع التقدم الكبير الذي حدث في العالم في السنوات الأخيرة فنحن الآن نستخدم الذكاء الاصطناعي في العلاج الإشعاعي، فبالاستناد إلى تقنية الذكاء الاصطناعي يتم تحديد موقع الورم السرطاني بدقة وهذا يؤدي لتقليل مخاطر التعرض للعلاج الإشعاعي للأنسجة والأعضاء المجاورة، ومع هذا التطور الذي شهده المركز بصورة خاصة ومؤسسة حمد الطبية بصورة عامة فهذا زاد ثقة المرضى لدينا وأسهم في خفض نسبة المرضى من المواطنين القطريين الذين يتوجهون للعلاج في الخارج.

- الصيدلية الجديدة
هل لكم أن تحدثونا عن الصيدلية المتطورة لتحضير الأدوية المعقمة التي افتتحت مؤخراً؟
إنَّ الصيدلية التي أفتتحت في مركز علاج وأبحاث السرطان تعد فريدة من نوعها في منطقة الشرق الأوسط وشمال أفريقيا بما فيها من الغرف المعقمة التي تضمن المعايير العالمية، وصُممت بمنتهى الدقة والالتزام بالمعايير الدولية خاصة من حيث الإرشادات التي وضعتها الهيئات العُليا للتعقيم المضاعف للعلاج الكيميائي، وهذا بدوره يزيد من قدرة القسم على إنتاج العلاج الكيميائي بنسبة 67% والعلاج الوريدي بنسبة 100% مما يعود بالنفع على مرضانا ويسمح لهم بالحصول على أدويتهم بصورة أسرع وأكثر راحة، وتلتزم الوحدة الجديدة بأكثر المعايير صرامة والتي يضعها دستور الأدوية الأمريكي وهو منظمة علمية مستقلة وغير ربحية تركز على بناء الثقة في مجال الإمداد الآمن وجودة الدواء، وتعنى الصيدلية بتحضير الأدوية في بيئة معقمة، وتستخدم تقنيات تحضير الأدوية المعقمة التي سيتم إعطاؤها عن طريق الحقن مثل العلاج الكيماوي والمضادات الحيوية وغيرها.
هل ترون جدوى من لقاح فيروس الورم الحُليمي سواء للذكور أو الإناث في خفض معدلات بعض أنواع السرطانات؟
إن فيروس الورم الحليمي البشري ليس السبب الوحيد لسرطان عنق الرحم بل هو من بين الأسباب المعروفة، لذا فان إعطاء اللقاح للوقاية من هذا الفيروس سيسهم في خفض معدلات الإصابة بسرطان عنق الرحم، والأورام المرتبطة بفيروس الورم الحُليمي البشري كسرطان البلعوم الأنفي.
- البحث السريري والخدمات
ما مدى أهمية البحث السريري لتطوير التشخيص والعلاج؟
إنَّ البحث الطبي من أهم الركائز التي يستفيد منها الأطباء على مستوى عالمي، ولها دور في اكتشاف العلاجات، فالبحث الطبي مهم أما الأبحاث التي نقوم بها هنا في دولة قطر فهي تسهم بإفراز نتائج جيدة، وقد أفتتح من فترة قريبة "مركز الرعاية الطبة والبحوث" لإجراء البحوث السريرية لتطبيق العلاجات على مرضى من المجتمع مما سيساعدنا على معرفة فعالية العلاجات المستخدمة، ومناسبتها وفعاليتها في المجتمع القطري.
هل خدمات السرطان تقدم لديكم فقط ؟
إنَّ مركز علاج وأبحاث السرطان هو المستشفى الأول الذي يقدم خدمات علاج السرطان في الدولة، إلا أنَّ هناك عددا من العيادات الموزعة على المستشفيات التابعة لمؤسسة حمد الطبية للتسهيل على المرضى كمستشفى الوكرة، مستشفى الخور، مستشفى الكوبي، مستشفى حزم مبيريك ومستشفى عائشة بنت حمد العطية، والهدف من هذه العيادات هو للعلاج في حال كانت الحالة مستقرة، أما الحالات التي تحتاج لعلاجات متقدمة فيتم تحويلها إلى مركز علاج وأبحاث السرطان.
- كلمة أخيرة
هل هناك من كلمة تحب أن توجهها لأفراد المجتمع من خلال "الشرق" ؟
أودَّ تحذير أفراد المجتمع من الانسياق وراء العلاجات الشعبية والخلطات التي تُسوق عبر وسائل التواصل الاجتماعي على أنها علاج للسرطان فأضرارها أكثر من منافعها، مع ضرورة الإقلاع عن التدخين بالنسبة للمدخنين حيث انَّ الدراسات تؤكد أنَّ 30% من وفيات مرض السرطان هم من المدخنين إلى جانب الحصول على لقاحات كفيروس الكبد الوبائي، ولقاح فيروس الورم الحُليمي البشري، وتجنب الأطعمة المصنعة، وتبني أنظمة صحية تعتمد على الرياضة والطعام الصحي المتوازن.
وأشير إلى أهمية الثقة بالمنشآت الصحية الوطنية وقدرتها على توفير العلاجات كافة من علاجات كيميائية وعلاجات دوائية وعلاجات مناعية، كما أصبحت هذه العلاجات الحديثة لها دور كبير في علاج كثير من أمراض السرطان، وهذا - بفضل الله - ثم بسبب التطور في التشخيص والعلاج، فمرض السرطان كأي مرض آخر له علاج في حال اكتشف في وقت مبكر، فيجب أن يتبدد الخوف المفرط من هذا المرض، وتكون هناك ثقة بوجود العلاجات المثبتة علميا.

بالأسماء.. تعرف على موظفي الجهات الحكومية الأكثر إنجازاً للخدمات الشهر الماضي
أظهرت بيانات الإنجاز الحكومي لشهر نوفمبر 2025، التي أصدرها ديوان الخدمة المدنية والتطوير الحكومي، تفوقًا ملحوظًا لعدد من... اقرأ المزيد
332
| 15 ديسمبر 2025
رئيس مجلس الوزراء يهنئ ملك البحرين
بعث معالي الشيخ محمد بن عبدالرحمن بن جاسم آل ثاني رئيس مجلس الوزراء وزير الخارجية، برقية تهنئة إلى... اقرأ المزيد
196
| 15 ديسمبر 2025
سمو نائب الأمير يهنئ ملك البحرين بمناسبة ذكرى اليوم الوطني لبلاده
بعث سمو الشيخ عبدالله بن حمد آل ثاني نائب الأمير، برقية تهنئة إلى صاحب الجلالة الملك حمد بن... اقرأ المزيد
144
| 15 ديسمبر 2025
مساحة إعلانية
مساحة إعلانية
كشف المجلس الوطني للتخطيط أن عدد السكان داخل دولة قطر بلغ في نهاية شهر نوفمبر (3,340,858) نسمة. وبذلك يرتفع عدد سكان دولة قطر...
86824
| 13 ديسمبر 2025
أعلنت وزارة الداخلية عن إطلاق مشروع استبدال لوحات المركبات بلوحات أرقام جديدة تحمل تصميماً مطوراً يتماشى مع أفضل المعايير الدولية ويدعم التقنيات الحديثة...
15632
| 12 ديسمبر 2025
أعلنت وسائل إعلام سعودية عن وفاة عبدالله آل عاطف مشهور سناب شات باسم أبو مرداع، فيما أُصيب صديقاه أبو حصة ودخيل، إثر تعرضهم...
14538
| 12 ديسمبر 2025
أكد العقيد الركن علي حسن الكعبي، مساعد مدير إدارة شؤون التراخيص بالإدارة العامة للمرور أن مشروع استبدال لوحات أرقام المركبات يمثل مرحلة جديدة...
13792
| 13 ديسمبر 2025
مساحة إعلانية
مساحة إعلانية
استقبلت رابطة رجال الأعمال القطريين، اليوم، وفدا سورياً برئاسة الدكتور حازم الشرع نائب رئيس المجلس الأعلى للتنمية الاقتصادية، بحضور السيد طلال الهلالي مدير...
128
| 14 ديسمبر 2025
أعلنت شركة وقود عن إعفاء جميع عملائها، من شركات ومؤسسات وأفراد، من رسوم شراء وتركيب شريحة وقودي، وذلك اعتبارًا من 1 يناير 2026....
2408
| 14 ديسمبر 2025
أعلنت شركة ودام الغذائية عن نتائج اجتماع الجمعية العامة غير العادية الذي عقد اليوم الموافق في 14/12/2025 حيث تمت الموافقة على الآتي: -...
976
| 14 ديسمبر 2025
اختتم مركز قطر للتكنولوجيا المالية، التابع لبنك قطر للتنمية، فعاليات يوم عرض المشاريع للفوج السابع من الشركات المتخرجة من برنامجي ما قبل تسريع...
90
| 14 ديسمبر 2025
مساحة إعلانية
تابع الأخبار المحلية والعالمية من خلال تطبيقات الجوال المتاحة على متجر جوجل ومتجر آبل




حذرت الأرصاد الجوية من أمطار متوقعة الأيام المقبلة بسبب تعمق المنخفق الجوي على شبه الجزيرة العربية مرة أخرى، منبهة إلى أن موجة الأمطار...
11158
| 14 ديسمبر 2025
نبهت إدارة الأرصاد الجوية إلى التقلبات الجوية المتوقعة، مع توقعات بفرص أمطار رعدية مصحوبة برياح هابطة قوية خلال الأيام المقبلة. ودعت الإدارة جميع...
5204
| 13 ديسمبر 2025
بلغت منتخبات الأردن والسعودية والمغرب والإمارات نصف نهائي بطولة كاس العرب لكرة القدم 2025 التي تقام حاليا في قطر وتستممر حتى 18 ديسمبر/كانون...
3646
| 13 ديسمبر 2025